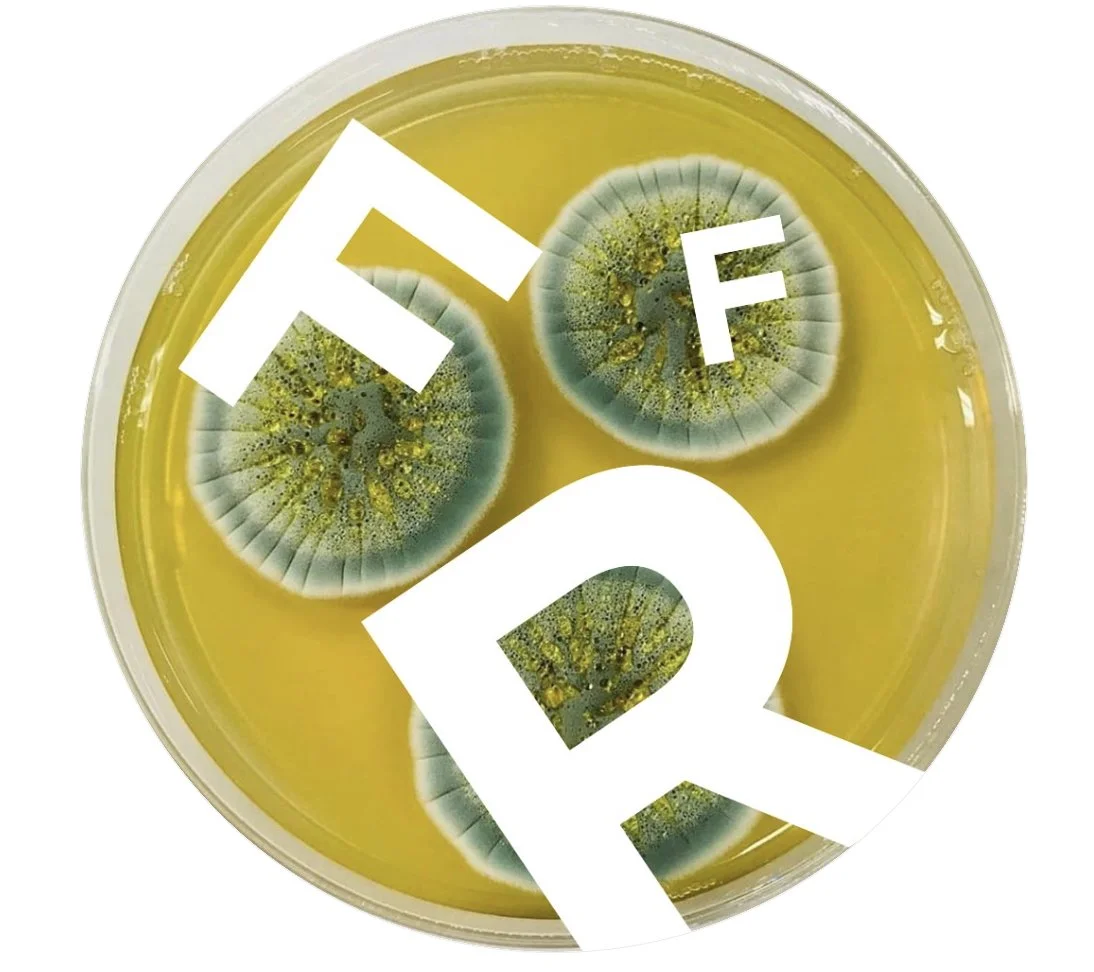

Rodolfo Ferrari Foundation
In synergy with the essence of the place, called to research in the medical field since its foundation in 1947, LABÒ is a laboratory that expresses itself in its true essence: an experimentation process that starts from an idea or a concept to become a product or an artwork.
Nestled in the industrious Milan, LABÒ derives its name from its location. In 1947, Prof. Rodolfo Ferrari established SPA Società Prodotti Antibiotici and became one of the first to produce antibiotics in Italy. Several years later, his granddaughter Alisée Matta, herself a creator, decided to dedicate the now unused Pharmacology section and other unused spaces to promote creation in the broad sense.
As stated in the manifesto of the Rodolfo Ferrari Foundation, in fact, “scientific and artistic research use different methods and languages, but share the same desire: to make the invisible visible. On the one hand, there is the scientific method that is made of rigour, of reproducible and certain processes; on the other hand, the artistic method, which works with visual associations, experiments in a free way, measuring itself with the indeterminate, with events not necessarily rational. The two researches, apparently so distant, have one element in common: intuition. It opens to change, moves sensitivity and consciousness”.

LABÒ
BY THE DESIGN BLENDER
In 2023, marked by a long friendship, Alisée Matta entrusted Elsa Lemarignier and François Leblanc di Cicilia with the responsibility of promoting this new venture. Surpassing the time capsule effect caused by the buildings and some rooms, we are quickly caught by the power of architectures, and the breath of live of machines still on site.
The 2024 edition has been under the responsibility of a dedicate company, The Design Blender corporation, under the curation of Elsa and François, always in partnership with SPA and Fondazione Rodolfo Ferrari. And for 2025, again, The Design Blender has the real chance to work closely with Ms Lyne Cohen Solal, leading figure of the design in the city of Paris, for the selection of creators and artisans of high manufacturing pieces.
The curator’s choice will be based on this climate of work, wealth creation and research. Alterity of forms and time, diversity of materials; in short, an exhaustive representation of a time of design, its richness in the respect of know-how and designers or craftsmen forms the guiding line of the presentation. Authentic, historic and contemporary creations will enable visitors to embrace 50 years of design, to discover new talents and demanding editors, attentive to the beautiful gesture.
